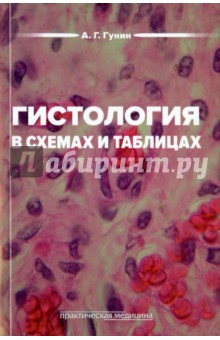
Гистология в схемах и таблицах. Учебное пособие - Андрей Гунин

|
|
Главная » 2016 » Сентябрь » 07

Издательство: Материк, 2002 г. Серия: Россия ХХ век
Аннотация к книге "Дети ГУЛАГа. 1918-1956"
Документы, представленные в сборнике, свидетельствуют о трагической судьбе детей в стране "счастливого детства". Общая репрессивная система СССР, разрушившая миллионы семей, обрекла маленьких граждан на сиротство, страдания и гибель.
|

Автор: Балашова Т. В. Редактор: Фридштейн Ю. Г. Издательство: Центр книги Рудомино, 2011 г.
Аннотация к книге "Испанские мотивы в русской поэзии ХХ века"
От первых поэтических строф, воссоздавших образ Испании на рубеже XIX-XX веков, к нашим дням идут параллельно два взаимосвязанных процесса: познание страны, ее обычаев, испанского национального характера, и одновременно - вопреки различию поэтических традиций - все более органичное восприятие образов испанской культуры, соединение далеких, казалось бы, ситуаций и переживаний, осмысление общности судеб стран и отдельных людей. Составление вступительная статья: Балашова Т.В.
|

16+ Автор: Монро Люси Переводчик: Милицкая Е. Издательство: Центрполиграф, 2015 г. Серия: Любовный роман
Аннотация к книге "Не обязан жениться"
Любовь никогда не была смыслом жизни для принца Максима. Королевской семье нужен наследник, и, когда возлюбленная Максима Джиллиан сообщает, что не может иметь детей, он решает прекратить с ней отношения. Чем обернется для Максима последняя ночь с Джиллиан?
|

Автор: Дьячкова Галина Издательство: Корифей, 2005 г. Серия: Для преподавателей Жанр: Математика. 2 класс и др.
Аннотация к книге "Устный счет в начальной школе"
Данное пособие представляет собой великолепные методические рекомендации по обучению учащихся начальной школы устному счету. Материал расположен по уровням сложности в соответствии с темами уроков, охватывает все разделы математики с 1 по 4 классы. Автор предлагает особые приемы устного счета, которые способствуют успешному усвоению материала, развитию у учащихся логического мышления.
|

Автор: Чехов Антон Павлович Художник: Черноглазов Владимир Юрьевич Издательство: Самовар, 2014 г. Серия: Школьная библиотека
Аннотация к книге ""Каштанка" и другие рассказы"
Вашему вниманию предлагаются рассказы А. П. Чехова. Произведения печатаются без сокращений. Для детей младшего школьного возраста.
|

16+ Автор: Кивинов Андрей Владимирович Редактор: Пименова В. Издательство: АСТ, 2014 г. Серия: Мастера криминальной прозы
Аннотация к книге "Зона личной безопасности. Испытательный срок"
Новобранец отдела собственной безопасности полиции Роман Фокин проходит испытательный срок. Первое же дело ставит его перед серьезным выбором. Человек, спасший ему жизнь, подозревается в убийстве. И теперь только от Фокина зависит, будет ли преступление раскрыто и останется ли он в рядах борцов с оборотнями... Не существует испытательных сроков. Каждый день жизни - испытание.
|

16+ Автор: Самаров Сергей Васильевич Издательство: Эксмо, 2014 г. Серия: Спецназ ГРУ/тв
Аннотация к книге "Зомбированный город"
Профессор военного НИИ Игорь Страхов изобрел электромагнитный излучатель, с помощью которого можно "программировать" людей на совершение тех или иных действий. Лабораторные испытания аппарат прошел блестяще, настало время испытать чудо техники в боевых условиях. В составе отряда спецназа ГРУ Страхов отправляется в горы для участия в операции по уничтожению крупной банды боевиков. При помощи излучателя удается "перепрограммировать" боевиков, и те убивают друг друга. Удовлетворенное начальство приказывает Страхову опробовать аппарат в условиях города. Профессор с азартом берется за дело, не подозревая, к каким катастрофическим последствиям приведет испытание излучателя в мегаполисе..
...
Читать дальше »
|

16+ Автор: Стрельникова Кира Издательство: Альфа-книга, 2015 г. Серия: Романтическая фантастика
Аннотация к книге "Сапфировые звёзды. Изумрудные искры"
Юффиль де Фродан по прозвищу Ручеек даже не думала, что всего лишь один обед в обществе короля круто изменит ее жизнь. О нет, между ними не вспыхнула долгая и крепкая любовь, ведь так бывает только в сказках, да и детская восторженная влюбленность Юффи всего лишь через год сошла на нет. Когда Ручеек вернулась во дворец, охранять иностранную гостью, она и не подозревала, что следующая встреча с королем… снова изменит ее жизнь. К лучшему ли? Или ей уготована всего лишь участь фаворитки? Левидия и Элетта де Ширр и не подозревали, какие сюрпризы принесет им обычная летняя поездка к тетушке за город и что они окажутся втян
...
Читать дальше »
|

Издательство: Эксмо, 2006 г. Серия: Для дома, для семьи
Аннотация к книге "Лекарственные средства для повышения иммунитета"
В справочнике представлены сведения о современных лекарственных средствах и о препаратах, содержащих витамины и минеральные вещества, применяемых для повышения иммунитета. В описании каждого препарата содержится полная информация: состав, формы выпуска, лечебные свойства, показания к применению, правила применения, возможные побочные эффекты, противопоказания, взаимодействие с другими медикаментозными средствами и алкоголем, а также возможность использования при беременности и грудном вскармливании. Для облегчения работы со справочником в него включены алфавитный указатель и указатель по фармакотерапевтическим группам, в котором лекарства расположены по их фармаколог
...
Читать дальше »
|

Автор: Щупов Андрей Издательство: Азбука, 2003 г. Серия: Правила боя
Аннотация к книге "Время палача: Роман"
Он - человек и тем не менее явился на Землю из другого мира. Он способен лечить любые болезни и наделен умениями, о которых трудно даже мечтать. Он видит истинную суть человека, и его невозможно обмануть. Он знает об опасности, нависшей над землянами, и хочет ее предотвратить. Увы, на его пути встают люди - добрые и злые, но другого выхода нет. Он вынужден выносить один приговор за другим.
|

Автор: Гербова В.В., Гербова Валентина Викторовна Редактор: Дорофеева Альфия Издательство: Мозаика-Синтез, 2011 г. Серия: Библиотека программы: Конспекты
Аннотация к книге "Занятия по развитию речи. Старшая группа"
В пособии представлены примерные планы занятий по развитию речи и приобщению детей 5-6 лет к художественной литературе; даны рекомендации по организации и проведению занятий. Книга адресована широкому кругу работников дошкольного образования, а также студентам педагогических колледжей и вузов.
|

Автор: Бушков Александр Александрович Редактор: Кузьмин В. В. Издательство: ОлмаМедиаГрупп/Просвещение, 2014 г. Серия: Пиранья
Аннотация к книге "Голая королева. Белая гвардия-3"
Все могут короли! Но все ли могут юные королевы?.. Игра подходит к концу - в стремительном эндшпиле королевская свита покидает поле битвы. Фигур для рокировок больше нет. Без пяти минут королева Натали Олонго и ее верный офицер - "великолепный Констан", а вроде бы - проходная пешка. Каким будет конец игры - победа или поражение? …Или ничья, если вдруг чей-либо триумф в принципе невозможен.
|

Автор: Комарова Юлия Александровна, Перретт Жанн, Ларионова Ирина Владимировна Художник: Бейзе Гетель, Impey Martin, Kenyon Tony все, Peet David, Stockham Jessica, Walker Shirley, Канурина Наталья скрыть Издательство: Русское слово, 2012 г. Жанр: Английский язык. 2 класс и др.
Аннотация к книге "Комплект демонстрационных карточек к уч. Комаровой, Ларионовой "Английский язык. Brilliant". 2-4 кл"
Комплект демонстрационных карточек является компонентом учебного курса "Английский язык. Brilliant" для 2-4 классов общеобразовательных учреждений (авторы Ю.А.Комарова, И.В.Ларионова, Ж.Перретт). Демонстрационные карточки содержат лек
...
Читать дальше »
|

Автор: Пушнова Наталия Издательство: Вагриус, 2007 г. Серия: Двое
Аннотация к книге "Миронов и Голубкина"
Талантливая драматическая актриса Лариса Голубкина привыкла во всем и всегда идти своей дорогой. Сама выбирала профессию, сама поступала в ГИТИС, сама добивалась признания зрителей. Красавица, органичная и на сцене, и на экране, она никогда не была обделена мужским вниманием. Почему же Голубкина выбрала именно Миронова? Согласно легенде, Миронов родился на сцене, на сцене и умер. Он ненавидел говорить о личной жизни. И потому вопрос о его спутнице интриговал публику в течение многих лет. Почему Миронов добивался руки именно Голубкиной? Ответы в книге Н. К. Пушновой, которая раскрывает истинную историю любви бессмертного Фигаро и обворожительной Шурочки Азаровой.
|

Автор: Гаевская Лариса Яковлевна Издательство: ОлмаМедиаГрупп/Просвещение, 2012 г. Серия: Кулинария (подарочная)
Аннотация к книге "Домашние заготовки на зиму"
Оригинальные рецепты домашних заготовок из ягод, фруктов и овощей, а также практические советы и авторские рекомендации вы найдете в этой книге. О том, как сохранить вкус и аромат, полезные свойства продуктов, вы узнаете от опытной хозяйки. Для широкого круга читателей.
|

Автор: Сопина Зоя Евгеньевна, Фомушкина Ирина Александровна Издательство: ГЭОТАР-Медиа, 2011 г.
Аннотация к книге "Управление качеством сестринской помощи"
Учебное пособие составлено в соответствии с государственным образовательным стандартом по специальности "Сестринское дело" (повышенный уровень). В нем представлены теоретико-методологические подходы к определению, оценке и управлению качеством. Авторами предпринята попытка обобщить опыт теории и практики управления качеством и применить его в сестринской практике с учетом специфических особенностей деятельности медицинской сестры. Издание состоит из трех частей: теоретического материала, практикума и приложений. Пособие рекомендовано студентам, обучающимся по специальностям 060109.51 и 060109.52 "Сестринское дел
...
Читать дальше »
|

Издательство: Юнион-паблик, 2006 г. Серия: Раскраски
Аннотация к книге "Орнитоптера. Живой мир Австралии"
Животный мир Земли многообразен и удивителен. Континенты нашей планеты имеют не только собственные природные и климатические особенности, но и уникальную фауну. Книжки-раскраски предназначены для детей дошкольного и младшего школьного возраста. Эти книги в простой и доступной для восприятия форме позволят ребенку: - Узнать о животных что-то новое и интересное; - Дадут достоверные сведения о внешнем облике, особенностях жизни и поведения животных; - Привьют ребенку начальные навыки самостоятельной работы; - Сформируют цельный образ животного мира планеты Земля. Для раскрашивания фломастерами.
|

16+ Автор: Новодворская Валерия Редактор: Чуткова Виктория Издательство: Захаров, 2015 г. Серия: Современная публицистика
Аннотация к книге "Избранное. В 3-х томах"
Публицистическое и литературное наследие Валерии Ильиничны Новодворской непросто уместить в трех томах. Она писала всю жизнь - от руки - обо всем: Пушкине, Чехове, российской истории и французской политике, о моде, театре, музыке - невозможно всего перечислить. Ее интересовали все и всё, она не проходила мимо ни одного мало-мальски значительного события не только в России, но и в мире. Написанное ею исчисляется тысячами страниц; это из того, что сохранилось, а многое она выбрасывала, да и черновиков почти не осталось. Принцип расположения материалов в этом издании - хронологический. Значительная часть текстов, причем не т
...
Читать дальше »
|

Автор: Фрай Макс Издательство: Амфора, 2010 г. Серия: Лабиринты EXO
Аннотация к книге "Жертвы обстоятельств"
Перед вами очередная часть культовой фантастической саги девяностых, где всякий найдет лишь то, что готов отыскать. Детективный сюжет и фантастические обстоятельства, брутальный казарменный юмор и тонкая постмодернистская ирония, устрашающие правила нового самурайского кодекса и практические советы начинающему городскому шаману, ваши собственные детские сны и ваши будущие стариковские сожаления, - все это и многое, многое другое сулит вам веселый рассказчик, лукавый оборотень по имени Макс Фрай.
|

Автор: Кюрти Ильдико Переводчик: Стеженская Т. Редактор: Гущенко Ирина Издательство: Амфора, 2004 г. Серия: Романтическая комедия
Аннотация к книге "Сердечный трепет"
Они совершенно не подходят друг другу. Он преуспевающий адвокат, а у нее свое кафе в Гамбурге. Его переполняют нереализованные желания, а она пытается в них разобраться. Он любит свою мебель, а она - свои проблемы. И при этом оба любят друг друга. Но в одно проклятое утро все рушится в одночасье. С разбитым сердцем садится она в машину, одержимая жаждой мести. Тем более что завтра ей исполнится 32 года.
|

0+ Автор: Злотников Виталий Художник: Сучилина И. Издательство: Стрекоза, 2013 г. Серия: Читаем по слогам
Аннотация к книге "Подарок для самого слабого"
Серия "Читаем по слогам" с занимательными историями и красочными иллюстрациями - прекрасная тренировка слогового чтения, которое поможет затем вашему ребенку научиться читать самостоятельно. Для детей дошкольного и младшего школьного возраста. Для дошкольного и младшего школьного возраста.
|

Автор: Кацир Иегудит Переводчик: Борухов Б. Издательство: Текст, 2008 г. Серия: Первый ряд
Аннотация к книге "А облака плывут, плывут... Сухопутные маяки"
Иегудит Кацир стоит в ряду лучших прозаиков современного Израиля. Ее произведения неизменно становятся бестселлерами, они переведены на многие языки, а книга "Сухопутные маяки" (1999), две повести из которой вошли в настоящее издание, выходила в Израиле семь раз. Кацир пишет о людях, находящихся на распутье, переживающих серьезный возрастной и духовный кризис. Они пытаются осмыслить свою жизнь и отчаянно ищут выход из тупика. Автор с редкой откровенностью и смелостью описывает самые интимные переживания своих героев.
|

Автор: Кочеткова Н. Издательство: Гном, 2005 г.
Аннотация к книге "Я различаю буквы О-А, сходные по написанию: альбом ученика"
Вниманию педагогов предлагается практический материал по преодолению моторной дисграфии. Задания, предложенные в данном пособии, помогут развить тонкие зрительно-моторные координации руки, уточнить и расширить объем зрительной памяти, развить зрительный гнозис и уточнить оптико-пространственные представления у детей - учащихся начальных классов массовых школ.
|

Автор: Мальцева Ирина Владимировна Художник: Шендрик Светлана Редактор: Измайлова Елена Издательство: Клевер Медиа Групп, 2015 г. Серия: Первое чтение: учимся быстро
Аннотация к книге "Я читаю и понимаю слова. ФГОС"
Новая книга "Я читаю и понимаю слова" как нельзя лучше подходит для обучения детей чтению. Интересные задания и подборки слов от простого к сложному: сначала читаем односложные слова и выбираем обобщения, далее слова из двух слогов, учимся составлять пары слов, отмечая нужные варианты карандашами, а специальная обучающая страничка, делает работу с книгой понятной каждому родителю. Каждый разворот книжки "Я читаю и понимаю слова" содержит задания и картинки-подсказки, направляющие ребенка. Такая комбинация упражнений подобрана не случайно - именно при подобной подаче мат
...
Читать дальше »
|

Автор: Эшбах Андреас Переводчик: Набатникова Татьяна Редактор: Захаров Игорь Издательство: Захаров, 2006 г. Серия: Европейский триллер
Аннотация к книге "Один триллион долларов"
Вчера Джон Фонтанелли развозил в Нью-Йорке пиццу. Сегодня он - богатейший человек мира. Один триллион долларов. Миллион миллионов. Тысяча миллиардов. Денег больше, чем можно себе представить. Это состояние в течение пятисот лет собирало итальянское адвокатское семейство Вакки и управляло им до того дня, который был указан в завещании основателя состояния. С этими деньгами Джон может делать что хочет. Но может ли он теперь хоть кому-нибудь доверять? Джон наслаждается роскошной жизнью, пока в один прекрасный день не раздастся звонок от таинственного незнакомца, который утверждает, что знает, как применить наследство и исполнить
...
Читать дальше »
|

Автор: Костина Любовь Михайловна Редактор: Авидон И. Издательство: Речь, 2006 г. Серия: Практикум по психодиагностике Жанр: Детская психология
Аннотация к книге "Методы диагностики тревожности"
В данной книге анализируется проблема исследования уровня тревоги и тревожности, как у детей, так и у взрослых. В ней описываются методы, направленные на диагностику тревожности как самостоятельной характеристики, и личностные методики, в которых тренога и тревожность выступают как один из диагностируемых компонентов. Книга предназначена для психологов, педагогов, воспитателей, дефектологов, социальных работников, организаторов детского и семейного досуга, родителей.
|

Редактор: Демина Е. В. Издательство: ОлмаМедиаГрупп/Просвещение, 2013 г. Серия: Подарочные издания. Религии
Аннотация к книге "Хадисы о пророке Мухаммеде"
Хадисы - священные предания о жизни, чудесах и поучениях пророка Мухаммеда, являются одной из главных культурных ценностей исламского мира. Это не только заповеди для мусульман, желающих жить по Сунне, это мудрость, адресованная всему человечеству. В нашем сборнике хадисы представлены в литературной обработке, без исна-дов и ритуальных фраз, чтобы облегчить читателю восприятие старинных текстов. Свою главную задачу составитель видел в том, чтобы привлечь внимание современников к боговдохновешюй, гениальной личности пророка Мухаммеда, поразить их широтой его кругозора, четкостью проповедовавшихся им этических принципов и тем самым приблизить к пониманию подлинного духа исла
...
Читать дальше »
|

Автор: Монро Мацуо Издательство: Крылов, 2005 г.
Аннотация к книге "Научи меня умирать"
Если ты потерял все, чем дорожил, и встал по ту сторону закона; если обезьяна ведет с тобой философские разговоры, а маньяк-начальник отрезает тебе ухо - не отчаивайся. Это твой путь к просветлению. Сядь на берегу моря, выпей виски и расслабься. Когда жизнь катится в пропасть, подтолкни ее. Когда реальность выворачивается наизнанку, пошли ее к черту.
|

Автор: Караваев Роман Издательство: Ленинградское издательство, 2006 г. Серия: Боевая фантастика
Аннотация к книге "Недалеко от Земли"
Открытие нового способа перемещения в пространстве позволяет земному человечеству быстро, эффективно и экономично освоить ресурсы Солнечной системы. Казалось бы, и до звезд теперь рукой подать, все они ныне Недалеко от Земли. Но неожиданно первые исследователи наталкиваются на непреодолимое препятствие - таинственную Сферу, перекрывающую людям выход на галактические просторы. Мало того, астронавты, непосредственно столкнувшиеся с загадочным космическим феноменом, обретают фантастические способности, мгновенно ставящие их в ряд суперменов. Однако далеко не все астронавты. Что является причиной этого? Вопрос чрезвычайно важный и для ученых, и для политиков, и для спецслужб. За группо
...
Читать дальше »
|

Автор: Эфрон Ариадна Сергеевна Издательство: Алгоритм, 2012 г. Серия: Гении и злодеи Жанр: Деятели культуры и искусства
Аннотация к книге "Неизвестная Цветаева. Воспоминания дочери"
Судьба дочери Марины Цветаевой и Сергея Эфрона, Ариадны, талантливой художницы, литератора, полна драматизма. Эмиграция и жизнь почти впроголодь на чужбине, возвращение на желанную родину, и - Сибирь, тюрьма, лагерь, ссылка, откуда писала она письма Борису Пастернаку, давнему другу матери. Письма, полные души и ума, как отзывался о них поэт. "Когда меня не будет, то в моем архиве найдут пачки твоих писем, и все решат, что только с тобой я и дружил, " - писал ей Пастернак. Ариадна Эфрон оставила и необыкновенно интересное, блистательно написанное свидетельство о Марине Цветаевой - поэтесс
...
Читать дальше »
|

Автор: Остер Григорий Бенционович Издательство: АСТ, 2008 г. Серия: Малышам
Аннотация к книге "Любимые сказки и сказочные истории"
В этой книжке ты встретишься с теми, кого уже не раз видел на экране, - котенок по имени Гав, попугаем, мартышкой, слоненком, удавом, его длинной бабушкой и другими героями любимых мультфильмов, а также с веселым Пифом - озорным и очень изобретательным псом. Их придумал и написал о них множество историй писатель Григорий Остер, так что можно считать, что все они его дети. Одни живут в джунглях, другие - в лесу, а третьи в обыкновенном городском доме. И все-таки все они похожи на тебя и твоих друзей - так же любят играть и придумывать всяческие развлечения. Почитай, и ты в этом убедишься сам
|

Автор: Санд Жаклин Редактор: Аминова О. Издательство: Эксмо-Пресс, 2011 г. Серия: Шопинг-детектив
Аннотация к книге "Принцесса Конде"
Принадлежать к старинному влиятельному роду - и чести и проклятье. Анна Женевьева изведала это в полной мере. Она! еще очень молода, однако уже стала разменной монетой в политических играх отца и была отдана в жены беспринципному жестокому человеку. Юная принцесса не верит в любовь, ног случайная встреча меняет для нее все. Вот только суждено ли ей счастье, когда на избраннике Анны - сутана?..
|

Автор: Жукова-Гладкова Мария Редактор: Рубис О. Издательство: Эксмо-Пресс, 2012 г. Серия: Двойной крутой детектив
Аннотация к книге "Сокровище призраков. Женщины порочного князя"
"СОКРОВИЩЕ ПРИЗРАКОВ" Марина двадцать раз пожалела, что согласилась на неравноценный обмен жилья. Тогда ей казалось, такой счастливый шанс выпадает раз в сто лет. Но как выяснилось, с квартирой все не так просто. Во-первых, там обитают привидения, во-вторых, некто то и дело подбрасывает к двери трупы незнакомых мужчин. А главное - ходят слухи, будто в стенах спрятан клад, и не один. Поэтому многие отдадут полжизни, лишь бы заполучить квартирку… "ЖЕНЩИНЫ ПОРОЧНОГО КНЯЗЯ" Бизнес-леди Алла Афанасьевой очень не везет в личной жизни, а всё из-за бывшего одноклассни
...
Читать дальше »
|

Автор: Гармаш-Роффе Татьяна Владимировна Редактор: Рубис О. Издательство: Эксмо-Пресс, 2010 г. Серия: Детектив высшего качества
Аннотация к книге "Королевский сорняк"
"Так не бывает!" - твердила себе Тоня, когда красавец и богач Кирилл влюбился в нее, невзрачную кассиршу. Но его нежность смела все преграды, и Тоня отважилась поверить в сказку... Напрасно! Очень скоро она стала сомневаться в самом существовании и любви, и фирмы, и богатства Кирилла. Но зачем ему понадобилось разыгрывать спектакль перед Тоней?! Постепенно мелкие недоразумения превращаются в самый настоящий кошмар. Кирилл исчезает, но его тень преследует Тоню, жестоко наказывая за каждое ослушание. Раздираемая страхом, любовью и гордостью, она самонадеянно отказывается от помощи частного детектива Алексея Кисанова. Какая ошибка!!! Ве
...
Читать дальше »
|

Автор: Мэй Сандра Издательство: Панорама, 2010 г. Серия: Панорама романов о любви
Аннотация к книге "Лукавый ангел"
Консумация - это не проституция, как ошибочно полагают многие. Впрочем, и она может считаться довольно рискованной профессией, в чем и убедилась Элис Джексон, став свидетельницей двух жестоких убийств в респектабельном клубе "Маджестик". Теперь безжалостный убийца идет и по ее следу, и в целом мире не осталось никого, кто может помочь Элис... кроме мрачного и неразговорчивого отставного полицейского, который терпеть ее не может. Даже странно, как она ухитрилась в него влюбиться!
|

Автор: Трейвас Любовь Юрьевна Художник: Суханова М. В. Редактор: Титова И. В. Издательство: Фитон+, 2010 г. Серия: Иллюстрированные справочники
Аннотация к книге "Болезни и вредители хвойных растений"
Здоровые, ухоженные хвойные растения - гордость хозяев и прекрасное украшение приусадебного участка. Однако такого состояния растений добиться непросто: хвойные породы, как в природном лесу, так и в искусственных посадках, подвержены заболеваниям и повреждениям вредителями, сильно страдают от нарушения требований к условиям произрастания, особенно технологии посадки. Какова причина снижения декоративности хвойного растения, чем вызвана его болезнь или кто наносит ему вред, легко выяснить с помощью нового атласа-определителя, составленного опытным фитопатологом, научным сотр
...
Читать дальше »
|

Автор: Вощанов Павел Игоревич Издательство: Эксмо, 2010 г. Серия: Исторический триллер Жанр: Современная история России (с 1991 года)
Аннотация к книге "Тени за Кремлевской стеной, или Последний сон хозяина"
Павел Игоревич Вощанов родился в Москве в семье офицера советской разведки. Был самым молодым директором самого крупного строительного НИИ в стране. В 1991 году Вощанов становится пресс-секретарем президента Ельцина. Принимает активное участие в августовских событиях 1991 года, являясь автором многих обращений и воззваний новой власти к народу. Весной 1992 года он неожиданно для многих разрывает свои отношения с президентом России и уходит в журналистику... В настоящее время - независимый политический обозреватель ряда российских и зарубе
...
Читать дальше »
|

Автор: Ткаченко Елена Анатольевна, Рогова Е. М., Соболев А. С. Издательство: Вернера Регена, 2009 г. Серия: Менеджмент Жанр: Менеджмент. Управление предприятием
Аннотация к книге "Управление финансами предприятия в условиях кризиса"
В книге рассматриваются основные подходы к управлению предприятием в условиях экономического кризиса, раскрывается структура финансов предприятия и анализируются источники финансирования деятельности предприятия с учетом текущей ситуации а экономике, выявляются основные причины кризисов в деятельности предприятий, рассматриваются основные методы диагностики кризисов, предлагаются рекомендации по санации экономики предприятий, по оптимизации управления финансами: управление дебиторской задолженн
...
Читать дальше »
|

Автор: Ошо Багван Шри Раджниш Издательство: Весь, 2006 г. Серия: Уроки жизни (мини-книжки)
Аннотация к книге "Быть родителем нового ребенка. Даря свободу, уважая границы, помогая расти"
Каждый ребенок рождается с огромными возможностями, с огромным потенциалом… Весь этот мир может быть раем - нужно просто позволить каждому быть на своем месте. И все зависит от того, как мы будем воспитывать детей. Нужен новый человек, и новый человек принесет с собой рай, тот самый рай, который в прошлом мы надеялись обрести где-то в другой жизни. Рай возможен здесь и сейчас, но мы должны дать миру нового ребенка. Если вы поможете ребенку прийти к своей собственной уникальности, вы сослужите челов
...
Читать дальше »
|

Автор: Кремнева Светлана Юрьевна Издательство: Экзамен, 2009 г. Серия: Учебно-методический комплект
Аннотация к книге "Словарные диктанты: 3кл: к уч. Л.М.Зелениной, Т.Е.Хохловой "Рус. яз.: уч. для 3 кл. нач. шк. В 2 ч.""
Одним из важных направлений в работе учителя является работа со словарными словами. Данное пособие поможет организовать словарную работу на уроке, разнообразить её, сделать более интересной и познавательной для учащихся. В этом сборнике представлены разные виды диктантов: выборочные, комбинированные, зрительные, цифровые, буквенные, слуховые, творческие и другие. Пособие может использоваться не только учителями, но и родителями, жел
...
Читать дальше »
|

Художник: Дорофеев И. К., Тарасова Н. В. Переводчик: Гаспаров М., Ганзен Анна Васильевна Издательство: Лада/Москва, 2014 г. Серия: Учебная литература Жанр: Родная речь. Чтение. 1 класс и др.
Аннотация к книге "Хрестоматия для начальной школы. 1-4 классы"
В сборнике представлены литературные произведения, входящие в программу по чтению и русскому языку в начальной школе. Составитель: Серова Екатерина Дмитриевна. 2-е издание, стереотипное.
|

Автор: Козачек А.В. Издательство: Феникс, 2008 г. Серия: Среднее профессиональное образование
Аннотация к книге "Экологические основы природопользования"
Учебное пособие по дисциплине "Экологические основы природопользования" разработано в соответствии с требованиями Государственных образовательных стандартов и с учетом положений диссертационных исследований по аспектам теории и методики организации экологического образования и воспитания, а также в соответствии с новейшими научными данными по проблемам природопользования. В пособии выделены два основных раздела. В первом разделе изучаются место природных ресурсов в природе и их значение для живой и неживой природы, их классификация, значение в хозяйственной деятельности человека, а также рассматриваются две глобальные пр
...
Читать дальше »
|

Автор: Кристи Агата Издательство: Амфора, 2005 г.
Аннотация к книге "Паутина: роман"
Роман "Паутина" представляет собой переработку одноименной пьесы А.Кристи. В переложении сохранены присущие драматическому произведению динамичность и напряженность действия. События развиваются быстротечно, один вымысел накладывается на другой, и паутина лжи постепенно, но неумолимо оплетает все уголки дома четы Хейлшем-Браунов.
|

Автор: Веденская Татьяна Евгеньевна Редактор: Дадаева А. Издательство: Эксмо-Пресс, 2012 г. Серия: В солнечном свете
Аннотация к книге "Пилюли от бабьей дури"
История знакомства Светы и Леры началась давно: с общежития второго московского меда. Обе оказались с Волги: одна - с верховья, вторая - с низовья. Обе мечтали о счастливом будущем. На этом их сходство, собственно, и заканчивалось. Красивая, уверенная в себе Валерия Орлович вызывала у робкой и наивной Светки восхищение. Именно поэтому предложила Светлана своей подружке, попавшей в беду, такое решение, на которое сама бы никогда не осмелилась. Думала ли Светка, как придется расплачиваться им обеим за удачно найденный выход!
|

Автор: Арефьева Т. А., Байкулова Н. Г., Пронина Ю. Г. все, Тимашова О. В., Сарафанова Наталья Алексеевна, Поимцева Наталья Алексеевна скрыть Редактор: Решетник Т. Издательство: Эксмо, 2010 г. Серия: Подарочные издания. Красота и здоровье Жанр: Макияж. Маникюр. Стрижка
Аннотация к книге "Большая книга красивой женщины"
При появлении первых морщин не нужно опускать руки, считая, что изменить уже ничего нельзя. В современном мире достаточно приемов, способных с легкостью не только любые проявления возраста, но и остановить процессы, ведущие к старению организма. И это можно сделать не только с помощью хирургических вмешательств. Авторы энциклопедии постарались подобрать простые рекомендации, кот
...
Читать дальше »
|

Автор: Кошман Т.И. Издательство: Феникс, 2007 г. Серия: Учение с увлечением
Аннотация к книге "Тексты для аудирования по английскому языку с проверочными заданиями: 5-11 классы"
Аудирование (тренировка слухового восприятия иностранной речи) способствует ее скорейшему освоению. Данное пособие предлагает не только тексты для прослушивания, но и краткий словарь к каждому из них, а также дифференцированный подход к оцениванию знаний.
|

Автор: Остен Эмилия Редактор: Аминова О. Издательство: Эксмо-Пресс, 2009 г. Серия: Нежные чувства
Аннотация к книге "Честь и лукавство"
Находясь в трудном материальном положении и не желая быть обузой для семьи, Эмма вынуждена согласиться на брак с богатым, но старым графом Дэшвиллом. Юная девушка готова следовать данным перед алтарем клятвам и посвятить уходу за больным мужем всю свою жизнь. Однако новоявленный супруг предлагает ей такое, что Эмме не остается ничего иного, как сначала воскликнуть: "Это просто чудовищно!", а затем согласиться с правотой графа...
|

Автор: Ломакович Светлана Владимировна, Тимченко Лариса Ивановна Художник: Рытман О. Б. Редактор: Мелкумянц В. Я. Издательство: Дрофа, 2011 г. Серия: Русский язык
Аннотация к книге "Русский язык. 2 класс. В 2 частях. Часть 1. Учебник"
Учебник имеет ярко выраженную коммуникативную направленность. В нём подобраны разнообразные задания, решающие задачи речевого развития учащихся. В учебнике представлена систематическая и планомерная орфографическая работа, которая обеспечивает формирование программных умений и навыков и применение их в реальных жизненных ситуациях. Содержание учебника соответствует авторской программе по русскому языку для 2 класса. Учебник рекомендован Министерством образования и науки Российской Федерации и вк
...
Читать дальше »
|
Автор: Гунин Андрей Германович Редактор: Проценко Дмитрий Дмитриевич Издательство: Практическая медицина, 2016 г.
Аннотация к книге "Гистология в схемах и таблицах. Учебное пособие"
Книга предлагает современный материал по гистологии, цитологии, эмбриологии, представленный в виде схем и таблиц. Содержание пособия соответствует программе по гистологии, цитологии и эмбриологии для медицинских вузов. Для студентов и преподавателей медицинских и биологических вузов, врачей.
|

Автор: Гаспарян Диана Издательство: Канон+, 2013 г.
Аннотация к книге "Философия сознания Мераба Мамардашвили"
Издание представляет собой первую в истории философии попытку системного изложения взглядов выдающегося российско-грузинского философа Мераба Мамардашвили на природу сознания. Текст настоящего русского издания является переводом книги, выпущенной на английском языке в США в 2011 г. В работе представлены главные вехи творчества философа и раскрываются ключевые пункты его исследовательской работы, непосредственно посвященной философии сознания. Рассматриваются следующие идеи философа: критика возможности создания позитивных теорий сознания, созданных по образцу естественнонаучных моделей, критический анализ классического понимания рефлексии и указание на невозможность
...
Читать дальше »
|

Автор: Татаринов Виталий Михайлович Редактор: Лебедева И. Г. Издательство: Владос, 2004 г. Серия: Библиотека музыкального руководителя Жанр: Песенники. Организация праздников
Аннотация к книге "Песни для детей на стихи Виталия Татаринова. Ласковая ласточка"
Сборник включает песни разной тематики известных отечественных композиторов: В. Кикты, М. Парцхаладзе, Т. Чудовой, Е. Попляновой. Песни адресованы детям дошкольного и младшего школьного возраста. Виталий Михайлович Татаринов - известный детский поэт, на стихи которого пишут песни лучшие отечественные композиторы. Веселые, остроумные стихотворения поэта населены забавными персонажами детских фантазий и игр, обладают особой, музыкальной энергетикой.
|

Автор: Клэр Дафна Издательство: Изд-во "Радуга", 2005 г. Серия: Любовный роман
Аннотация к книге "Не ускользай от меня: Роман"
Габриел Хадсон, любимец женщин и преуспевающий бизнесмен, решает приударить за случайно встреченной им молодой художницей и... получает отказ. Более того, девушка явно избегает его и вообще ведет себя довольно странно. Привыкший всегда добиваться своего, Гэбриел решает разобраться, в чем тут дело.
|

Автор: Макомбер Дебби Переводчик: Сидорова О. Д. Редактор: Глебовская Л. И. Издательство: Центрполиграф, 2010 г. Серия: Harlequin The Best
Аннотация к книге "Магазинчик на Цветочной улице"
Лидия Хофман шестнадцать лет боролась с тяжелым недугом и победила его с помощью самоотверженной любви родных, доброты друзей и… вязания. Теперь она - удачливая владелица магазинчика пряжи "Путеводная нить" на Цветочной улице - набрала первую группу на курсы вязания. Словно волшебная нить Ариадны прочно связала не знакомых прежде женщин. Общая энергия преодоления помогает блистательной Жаклин восстановить гармонию в семье и наладить отношения с простушкой-невесткой и "неверным" супругом, неформальной боевой Аликс найти надежную пристань в житейском море, а отчаявшейся в попытке родить ребенка Кэрол
...
Читать дальше »
|

Автор: Мешалкин Владислав Эдуардович, Баранцевич Евгений Робертович Издательство: Питер, 2009 г.
Аннотация к книге "Славянская гимнастика. Свод Здравы Стрибога. Свод Здравы Макоши. Практики волхвов (+DVD)"
Владислав Эдуардович Мешалкин - врач-инструктор оздоровительных групп по славянской гимнастике, специалист по восточным методам лечения, мастер ряда восточных единоборств. Много лет занимается исследованием боевого и целительского наследия славян. Вместе с главным неврологом Северо-Западного региона профессором Евгением Робертовичем Баранцевичем возглавляет программу фонда по изучению славянского целительского наследия "Славянская здрава". В славянской традиции
...
Читать дальше »
|

Автор: Кутузова Ирина Александровна Художник: Верженская В. В. Редактор: Иконникова Ю. В. Издательство: Просвещение, 2005 г. Серия: Дошкольный мир
Аннотация к книге "Что должен знать руководитель дошкольного учреждения"
Мтеодическон пособие для руководителей и воспитателей дошкольных образовательных учреждений. В пособии обобщен многолетний опыт работы методической службы и старейшего в стране центра дошкольного образования Санкт-Петербурга. Автор дает реекомендаци, как выбрать программу, обновить педагогический процесс в дошкольном учреждении, предлагает оригинальные конспекты занятий с дошкольниками. 3-е издание
|

Автор: Хаитов Рахим Мусаевич Издательство: ГЭОТАР-Медиа, 2016 г.
Аннотация к книге "Иммунология. Учебник"
В учебнике представлены современные сведения практически обо всех ключевых аспектах строения и функционирования системы иммунитета в норме и патологии. На организменном, клеточном и молекулярно-генетическом уровнях обобщены представления о факторах врождённого и механизмах формирования адаптивного (приобретённого) иммунитета. Даны сведения о популяциях клеток иммунной системы, рецепторных структурах иммуноцитов, механизмах формирования внутриклеточных сигнальных путей, главном комплексе гистосовместимости, генетическом контроле иммунитета, иммунологической памяти. Разобраны иммунодефициты, аллергические и аутоиммунные заболевания. Показана возможность фенотипической коррекции генетического контроля иммунного от
...
Читать дальше »
|

Автор: Вудолл Тринни, Константайн Сюзанна Переводчик: Пархомовская Н. Редактор: Яновская М. Издательство: Эксмо-Пресс, 2009 г. Серия: Фирменный стиль
Аннотация к книге "Как одежда может изменить вашу жизнь"
"Наша книга - это не славно подретушированный модный журнал, раздающий советы, как достичь совершенства. Это честный и правдивый рассказ о том, как посмотреть на себя со стороны и увидеть, где необходимы улучшения. Мы не верим рекламе (разве что речь идет о кофе!), поэтому вся информация в книге проверенная, испытанная на себе и здравая." Тринни Вудолл и Сюзанна Константайн
|

16+ Автор: Николаев Игорь Редактор: Ярусова Н. Издательство: Эксмо, 2015 г. Серия: Поэзия - Подарочные издания
Аннотация к книге "Я люблю тебя до слез"
"Пролистав эту подборку текстов и все-таки решившись на их публикацию, я представил себе некую игру с вами, читателями-слушателями, когда при чтении того или иного текста где-то внутри вас нажимается кнопочка "play" и начинает звучать голос той самой певицы или певца в той самой аранжировке, и вы переноситесь в ТО время и в ТЕ обстоятельства своей жизни, когда эта песня вас чем-то тронула, и ваши сердца обволакивает щемящее чувство ностальгии. Я это называю - слушать песню глазами. Но, конечно, намного точнее - слушать песню душой. Приятного прослушивания!" Игорь Николаев
|

Автор: Серова Марина Сергеевна Издательство: Эксмо-Пресс, 2006 г. Серия: Бестселлеры М.Серовой (мяг)
Аннотация к книге "Шкура неубитого медведя"
Молодой бизнесмен-компьютерщик Игорь Каменский узнает, что где-то в Швейцарии хранится в банковских сейфах золото промышленника Демидова аж на триста тысяч фунтов стерлингов в ценах 1917 года. А наследником состояния, судя по письму адвоката, является он, Игорь. Чтобы вступить в право наследования, Каменский под охраной телохранителя Евгении Охотниковой выезжает в... небольшой уральский городок. Путь к сказочному богатству оказался тернистым и едва не стоил им жизни. Ведь, кроме Игоря, обнаружился еще один наследник, который готов на все, чтобы стать единственным...
|

Автор: Бадрак Валентин Владимирович Редактор: Фомина Н. Е. Издательство: Фолио, 2011 г.
Аннотация к книге "Как достичь успеха и стать лидером"
Это книга-тренинг. Она научит вас пользоваться уникальными технологиями достижения успеха, которые применяли более 400 выдающихся личностей, ставших известными, знаменитыми, успешными. Эта книга для победителя!
|

Издательство: Вектор, 2006 г. Серия: Целительные практики. Энциклопедия
Аннотация к книге "Добрые советы для вашего здоровья"
Мы выбрали для вас лучшее! Эта книга станет вашим семейным доктором на долгие годы. Проверенные рецепты исцеления от многих недугов с помощью эффективных природных средств: - чайного гриба; - яблочного уксуса; - воды и глины. Авторские методики самых известных натуропатов России: - Е. Щадилова; - В. Востокова; - Н. Семеновой; - Г. Малахова; - А. Маловичко. ЧИТАЙТЕ И БУДЬТЕ ЗДОРОВЫ!
|

Автор: Аршавина Людмила Издательство: Невский проспект, 2003 г.
Аннотация к книге "Сделай себя красивой! Уход за кожей и волосами"
Оцените себя по достоинству! Пусть ваша кожа светится здоровьем, а волосы будут истинным украшением. Что для этого нужно? Пятнадцать минут в день и несколько практических советов. Советы вы найдете в этой книге, и не только советы. Множество рецептов косметических средств, методики самомассажа и особенности ухода за собой - все это с профессиональными комментариями опытного косметолога.
|

Автор: Мельник Маргарита Викторовна, Герасимова Елена Борисовна Редактор: Кутепова М. А. Издательство: Форум, 2008 г. Серия: Профессиональное образование Жанр: Банковское дело. Финансы
Аннотация к книге "Анализ финансово-хозяйственной деятельности предприятия"
Учебное пособие раскрывает основы комплексного экономического анализа как инструмента принятия управленческих решений. Теоретические и методические положения дополнены условными примерами, кейс-стади (ситуационными заданиями), в которых подробно раскрываются методики анализа разных сторон деятельности коммерческой организации и описываются расчеты по данным конкретных предприятий. Структура изложения материала нацелена на формирование у читателя комплексного представл
...
Читать дальше »
|

Автор: Алешина Наталия Алексеевна Издательство: Мир книги, 2008 г. Серия: Путеводитель по саду и огороду
Аннотация к книге "Островок красоты на вашем участке"
Это издание для садоводов, которым хочется не только собрать выращенный урожай, но и создать на своем участке райский уголок, где можно насладиться красотой и отдохнуть. В книге описаны виды и сорта цветов, а также деревьев и кустарников, которые хорошо приживаются в средней полосе России. Вы узнаете, как устроить цветники, разбить клумбу и газон, какие виды овощных культур способны придать вашему участку декоративное своеобразие.
|

Автор: Кочеткова А., Скворцов Я., Тарасов А. Издательство: Питер, 2006 г. Серия: Учебник для ВУЗов
Аннотация к книге "Теория и практика связей с общественностью"
Предлагаемый учебник посвящен актуальным проблемам развития и становления связей с общественностью, а также их инструментарию. Связи с общественностью представляют собой длительную и последовательную работу, нацеленную на создание репутации. В издании рассматривается широкий спектр вопросов - от исторических до прикладных. Особое внимание уделяется исследовательскому процессу как первому этапу планирования успешной PR-кампании. Обсуждаются способы проведения эффективной пресс-конференции, дается оценка наиболее сложных моментов, которые могут возникать как в процессе подготовки м
...
Читать дальше »
|

Автор: Могилевская Ангелина Павловна Издательство: Вектор, 2008 г. Серия: Школа счастья с Луизой Хей
Аннотация к книге "Сначала думай - потом богатей!"
Ангелина Могилевская - ученица Луизы Хей, самый известный проводник ее учения в России. Ее методика создана специально для российских слушателей и несет в себе энергию и опыт самого позитивного учения XX века. Новая книга Ангелины Могилевской - уникальное собрание материалов семинаров и тренингов, которые она проводила на протяжении нескольких лет. Изложенные в ней концепции помогут читателям оценить свое финансовое положение и понять, что нужно делать для его улучшения. Автор продолжает разговор о том, как научиться заменять негативные мысли и эмоции - позитивными, которые благотворно влияют не только на материальное пол
...
Читать дальше »
|

Автор: Лазарева Валерия Алексеевна Редактор: Безверхова А. С. Издательство: Дом Федорова, 2013 г. Жанр: Родная речь. Чтение. 3 класс
Аннотация к книге "Методические рекомендации к курсу "Литературное чтение". 3 класс. ФГОС"
Пособие предназначено для учителей, работающих по учебнику В. А. Лазаревой "Литературное чтение" для 3 класса, соответствующему требованиям ФГОС начального общего образования. В методических рекомендациях показаны подходы к анализу произведений, главные направления аналитической деятельности учащихся, даны вопросы к текстам, приведены разнообразные виды самостоятельных и творческих работ третьеклассников. Пособие раскрывает концепцию и структуру учебника и включает программу по лит
...
Читать дальше »
|

Редактор: Сухотина А. Л. Издательство: Астрель, 2013 г.
Аннотация к книге "Книга для настоящих девочек"
В этой книге ты найдешь надежные и проверенные советы и рекомендации, которые помогут тебе овладеть полезными навыками. Эта книга, без которой не обойтись ни одной девочке, научит тебя многим вещам, например как приготовить превосходные спагетти или как залатать прокол на шине твоего велосипеда. Для детей среднего школьного возраста
|

18+ Автор: Мэрфи Джозеф Переводчик: Бабук М. А. Издательство: Попурри, 2013 г.
Аннотация к книге "В молитве - ответ"
Молитва может решить все проблемы! Нужно только правильно молиться. Доктор Мэрфи применял специальные методы молитвы, найденные в Библии, которые на практике доказали свою эффективность во многих частях света. Простым и понятным языком автор объясняет, как следует относиться к другим людям и молиться о них. Эта книга является своего рода ключом к здоровью, процветанию, спокойствию духа, личным взаимоотношениям и оказанию конструктивной помощи другим людям.
|

Автор: Уинтерз Ребекка Издательство: Изд-во "Радуга", 2009 г. Серия: Любовный роман
Аннотация к книге "Зигзаги любви"
Гонщик мирового класса, итальянский аристократ Сезар де Фалкон и не подозревает о том, что у него есть сын. Он узнает об этом лишь после страшной аварии, прикованный к инвалидной коляске.
|

Автор: Нестерова Наталья Владимировна Издательство: Астрель, 2012 г.
Аннотация к книге "Испекли мы каравай"
Что в жизни может быть чудеснее нежных заботливых женских рук? Не трудитесь - придумать невозможно! Обычно о мастерах говорят: "У мужика золотые руки!" А то, что и у женщин руки могут не только укачивать ребенка, ласкать любимого, утешать страдающего, забывают. Героини этой книги все как одна кудесницы - их руки, на первый взгляд, творят обычные вещи: рисуют, ткут, пекут, мастерят, а на самом деле совершают восхитительное таинство, доступное тем, кто знает наслаждение творчеством. Мастеровому человеку нелегко добиться признания, а если этот человек женщина, то ему нелегко вдвойне. Счастье, если рядом оказывается спутник, чья любовь спаяна с восхищением талантом избранницы. Какие они, девочки-кудесниц
...
Читать дальше »
|

Автор: Шауб Игорь, Андерсен Владимир Издательство: Эксмо, 2008 г. Серия: Войны Древнего мира
Аннотация к книге "Спартанцы в бою"
Они были лучшими воинами Древнего мира. Легендарные спартанцы, чьи стойкость и мужество были воспеты в многочисленных свидетельствах древних, в доримский период заслуженно считались непревзойденными бойцами. Война была их жизнью. Само существование их родины - Спарты - было неразрывно связано с войной. Подобно акуле, всю жизнь проводящей в непрерывном плавании, спартанское общество не могло жить без постоянного притока новых территорий, богатств и, самое главное, рабов. Они сражались и умирали молча. Немногословные граждане Лаконии смогли создать небольшую, но очень сильную армию, которая в течение короткого времени огнем и мечом превратила Спарту в гегемона Эллады.
|

Издательство: Кнорус, 2012 г. Серия: Законы и Кодексы
Аннотация к книге "Семейный кодекс РФ по состоянию на 01.04.2012 года"
Текст Кодекса сверен с официальным источником и приводится по состоянию на 1 апреля 2012 года. Представленное вашему вниманию издание учитывает все изменения, внесенные опубликованными в официальных источниках федеральными законами. Текст статей приводится на дату, обозначенную на обложке данной книги (дата актуализации). Если есть изменения, вступающие в силу позднее, то вместе с редакцией нормы, действующей на эту дату, приводится норма в новой редакции и указывается дата, с которой она вступает в силу.
|

Автор: Алексеев Сергей Петрович Художник: Беланов Н. Редактор: Тумурова Т. Издательство: Астрель, 2012 г. Серия: Детская классика
Аннотация к книге "От Москвы до Берлина. Рассказы о Великой Отечественной войне"
Победа над фашистами в Великой Отечественной войне - бессмертный подвиг нашего народа. Автор этой книги Сергей Петрович Алексеев (1922 -2008) - участник этой войны, и каждый его рассказ - ещё один штрих тех судьбоносных событий, непреходящая боль о погибших друзьях и низкий поклон победителям. Откройте книгу, дорогие наши читатели, и вы окажетесь на полях сражений, среди битв и настоящих героев великой войны.
|

Автор: Кефалиди Иордан Художник: Черкашина Ольга Издательство: Азбука, 2013 г. Серия: Книжки-мальчишки
Аннотация к книге "Самолётик выступает на авиашоу"
Самолетика пригласили выступить на авиашоу. Он очень обрадовался и начал тренироваться. Но когда настал день авиашоу, Самолетик вдруг почувствовал себя таким неумелым по сравнению с другими участниками, что спрятался в ангаре. Кто же поможет ему преодолеть волнение? Для чтения взрослыми детям
|

Автор: Доктор Адаптор Редактор: Минаева Е. В. Издательство: Центрполиграф, 2010 г. Серия: Советы опытного доктора
Аннотация к книге "Очищение организма за 14 дней"
Эта книга посвящена очищению организма на всех уровнях - и на физическом, и на энергетическом. Автор разработал уникальную систему мягкого очищения и оздоровления, которая позволит вам избавиться от хронических болезней и вновь обрести отличное самочувствие за 14 дней. Не нужно мучить себя! Водные процедуры, комплекс упражнений и коррекция питьевого режима и питания способны восстановить ваше здоровье. Книга написана доступно и с юмором, и заниматься по ней будет легко и приятно.
|

Автор: Черепащук Анатолий Михайлович Издательство: Век-2, 2004 г. Серия: Наука для всех
Аннотация к книге "Вселенная, жизнь, черные дыры"
Человека всегда интересовало, где он живет, откуда это появилось, "есть ли жизнь на Марсе" и что со всем этим будет дальше. В предлагаемой книге изложено современное представление о возникновении и развитии Вселенной; о том, как ведутся поиски жизни вне Земли и о результатах этих поисков; о загадочных и фантастических свойствах черных дыр и о том, как их находят и "взвешивают"; о самых последних открытиях в астрофизике - антигравитации, "темной материи" и "темной энергии". Для чтения книги не требуется никаких специальных знаний, выходящих за рамки школьной физики.
|

Автор: Яковлев Вадим Издательство: ИД Третий Рим, 2006 г.
Аннотация к книге "Комментарии к Правилам дорожного движения Российской Федерации"
Издание содержит подробные и хорошо иллюстрированные комментарии к Правилам дорожного движения и включает в себя все изменения, введенные в действие в 2006 году, а также положения, вступающие в силу с 1 января 2007 года. В книге содержится более 300 цветных иллюстраций, помогающих лучше усвоить учебный материал. Книга предназначена для слушателей автошкол, а также людей, желающих самостоятельно изучить Правила дорожного движения, дорожные знаки, дорожную разметку и Основные положения по допуску транспортных средств к эксплуатации. Рецензент: помощник директора по науке НИИ автомобильног
...
Читать дальше »
|

0+ Художник: Горбунова И. В. Издательство: АСТ, 2015 г.
Аннотация к книге "Любимые сказки"
Все дети любят слушать сказки. Рассматривая картинки вместе с ребенком, вы можете придумать новую концовку любимой сказки или разыграть сказочное представление с помощью веселых наклеек. Сказочные уроки с наклейками развивают воображение, память и внимание, способствуют развитию речи, зрительного восприятия и мелкой моторики. Для дошкольного возраста. Текст читают взрослые.
|

Автор: Пройслер Отфрид Художник: Гольц Ника Георгиевна Переводчик: Коринец Юрий Иосифович Редактор: Кондрашова Л. Издательство: Эксмо, 2012 г. Серия: Книги - мои друзья
Аннотация к книге "Маленький водяной"
Сказка немецкого писателя Отфрида Пройслера полна приключений, озорных проделок, веселых шуток. Ее персонажи стараются пробудить в своих маленьких читателях самые лучшие качества: умение сострадать, желание делать добро, стремление понять другого. Для младшего школьного возраста.
|

Автор: Хаймз Честер Переводчик: Факторович Е. П., Ливергант Александр Яковлевич Издательство: АСТ, 2011 г.
Аннотация к книге "Беги, негр, беги! На игле"
Белый полицейский Уокер совершил двойное убийство, и, как на грех, свидетелем преступления стал необразованный черный паренек Джимми. Отныне против него все: и дружки убийцы, и вполне честные копы, желающие, чтобы он дал показания против Уокера - и не понимающие, что для Джимми это равносильно смертному приговору … Детективы Джонсон и Джонс попадают в сложную ситуацию - они потеряли след двух опасных преступников. Один из них - убийца-альбинос сбежал и находится в розыске. Вскоре погибает и его партнер по бизнесу - карлик-наркодилер Джейк, причем в убийстве обвиняют детектива Джонса. Но эта смерть - лишь начало в серии жестоких и загадочных убийств…
|

Автор: Ермаков Михаил Издательство: Азбука, 2003 г. Серия: Мир Востока
Аннотация к книге "Магия Китая. Введение в традиционные науки и практики"
Фэншуй. Книга Перемен. Акупунктура. Мануальная терапия. Ушу. Гунфу. Цигун. Последние пятьдесят лет эти китайские науки и практики активно применяются на Западе и в России, но все еще заключают в себе много неведомого и непознанного. Настоящее издание предназначено для читателя, занимающегося традиционными китайскими науками и практиками, а также для всех интересующихся культурой Китая.
|

Редактор: Соловьев А. И. Издательство: РОССПЭН, 2008 г.
Аннотация к книге "Управление государством: проблемы и тенденции развития. Политическая наука: Ежегодник 2007"
Помешенные в сборнике материалы освещают различные институциональные и неинституциональные процессы в системе государственного управления. В этом контексте раскрываются многообразные политико-административные, кадровые, ценностно-идеологические, правовые и иные механизмы формирования государственных стратегий, принятия политических решений в условиях реформирования аппарата управления. В книге также помещен ряд статей, посвященных некоторым другим актуальным проблемам политической науки.
|

Редактор: Жукова Ю. Издательство: Эгмонт, 2011 г. Серия: Наклей и раскрась!
Аннотация к книге "Наклей и раскрась "Маленькие Эйнштейны" (№ 1177)"
В этой книжке ребенка ждет встреча с героями мультфильма "Маленькие Эйнштейны". И это не только альбом с наклейками (16 цветных наклеек внутри), но и раскраска! Чтобы правильно раскрасить картинки, ребенок должен: 1.Найти страницу с тем же номером, что и на наклейке. 2.Вклеить наклейку в пустое поле. 3.Раскрасить картинку в те же цвета, что и на наклейке. Желаем успехов! Для детей дошкольного и младшего школьного возраста.
|

Редактор: Хлюпин Олег Издательство: Вако, 2015 г. Серия: Сборник Задач Жанр: Справочники, учебные пособия по английскому языку
Аннотация к книге "Английский язык. Сборник лексико-грамматических упражнений. 11 класс. ФГОС"
Сборник лексико-грамматических упражнений составлен в соответствии с требованиями ФГОС и предназначен для повторения и закрепления грамматических и лексических тем. Темы заданий сборника соответствуют школьной программе. Технологии выполнения заданий способствуют подготовке учащихся к сдаче государственной аттестации по английскому языку. Сборник предназначен для учителей английского языка и учащихся одиннадцатого класса общеобразовательной школы.
|

0+ Автор: Крупенчук Ольга Игоревна Художник: Ланская И. Редактор: Салимжанова Ф. Издательство: Литера, 2015 г. Серия: В помощь логопеду
Аннотация к книге "Логопедические задания для автоматизации и дифференциации свистящих звуков С, Сь, З, Зь и звука Ц"
Большая сложность для ребёнка состоит в том, чтобы следить за уже поставленными логопедом звуками не только при произнесении одного слова, но и при включении этого слова сначала в словосочетания, потом в предложения, двустишия и т. д. Главная цель всех предложенных к книге упражнений - настолько хорошо закрепить поставленный звук, чтобы ребёнок произносил его легко, не задумываясь каждый раз, авто
...
Читать дальше »
|

Автор: Соловова Елена Николаевна, Година Анна Борисовна, Пореченкова Екатерина Александровна Художник: Ямашкина А. В. Редактор: Соколова И. Е. Издательство: Экзамен, 2016 г. Серия: ЕГЭ Начальная школа Жанр: ЕГЭ. Английский язык
Аннотация к книге "Английский язык. Итоговая аттестация за курс начальной школы. Типовые тестовые задания. ФГОС (+CD)"
Данное пособие ориентировано на подготовку учащихся для успешной сдачи итоговой аттестации по английскому языку за курс начальной школы. В пособии предлагается модель итоговой аттестации по английскому языку за начальную школу, разработанная в соответствии с новыми ФГОС - Ф
...
Читать дальше »
|

Автор: Пазин Роман Викторович Издательство: Легион, 2016 г. Серия: Готовимся к ЕГЭ Жанр: ЕГЭ по истории и др.
Аннотация к книге "История. ЕГЭ. 10-11 класс. Анализ исторического источника"
Предлагаемое учебно-методического пособие адресовано старшеклассникам и содержит более 200 текстов исторических источников и прилагаемых к ним заданий высокого уровня сложности (в демоверсии ЕГЭ 2016 г. - задания № 20-22), а также модели ответов. Книга служит для подготовки к ЕГЭ по истории, но может использоваться и для текущего, тематического и промежуточного контроля обученности в 10-11-х классах, поскольку весь представленный материал сгруппирован по хронологическому принципу в тематические блоки. Систематическая работа с пособием позволит овладеть п
...
Читать дальше »
|

Автор: Берри Джейсон Переводчик: Завалов М. Редактор: Богословский А. Издательство: Эксмо, 2012 г. Серия: Религия. Война за Бога
Аннотация к книге "Деньги Ватикана. Тайная история церковных финансов"
Это сенсационное журналистское расследование призвано осветить одну из самых закрытых финансовых систем мира: как обращаются с деньгами в Ватикане. Что происходит с пожертвованиями верующих всего мира? Сколько имущества в собственности у Католической церкви на самом деле? Кто и как управляет финансами в Ватикане? Связана ли церковь с мафией? Вы узнаете, на чем и как зарабатывает церковь, как устроена финансовая система Ватикана и почему церковь не спешит ра свои бухгалтерские книги.
|

Автор: Полякова Татьяна Викторовна Издательство: Эксмо, 2008 г. Серия: Авантюрный детектив (тв)
Аннотация к книге "Держи меня крепче"
В жизни Ольги Рязанцевой по-прежнему царствуют трое мужчин… Один - первая любовь и босс, второй - ее муж и любовь настоящая, а третий… бывший любовник. Она всеми силами старается забыть его, но он не дает это сделать… После трагедии, случившейся с ней полгода назад, Ольга вышла замуж за Тимура Тагаева. Не успела она зализать раны, как снова попала в передрягу. Началось с того, что босс велел ей разобраться в гибели жены нового кандидата в мэры. Она утонула в собственном бассейне. В этом деле слишком много странностей, и Рязанцева со свойственной ей страстью ищет компромат на кандидата. А тут еще за Ольгой начинается слежка, враги ее бывшего любовника уверены: рано или поздно она
...
Читать дальше »
|

16+ Автор: Млечин Леонид Михайлович Редактор: Никифорова И. И. Издательство: Молодая гвардия, 2014 г. Серия: Жизнь замечательных людей
Аннотация к книге "Фрунзе"
Странная и неожиданная смерть молодого военного министра Советской России Михаила Васильевича Фрунзе поставила точку в его стремительной карьере в тот самый момент, когда перед ним открывались блистательные перспективы. Когда он умер в результате неудачно проведенной хирургической операции, зловещие слухи пошли по Москве: "Врачи зарезали..." Заговорили о том, что Фрунзе не нуждался в хирургическом вмешательстве, что его насильно уложили на операционный стол. И не для того, чтобы выздоровел, а совсем наоборот. Говорили, что военный министр оказался жертвой жестокой политической борьбы. История его недолгой жизни полна невероятных драматических поворотов. После смерти Ленина
...
Читать дальше »
|

Автор: Лихачев Юрий Григорьевич Редактор: Волкова Д. Издательство: Феникс, 2009 г. Серия: Учебные пособия для ДМШ
Аннотация к книге "Хрестоматия гитариста: этюды"
Чтобы легко и свободно музицировать, передавая те или иные образы посредством игры на инструменте, необходимо имеет хорошую техническую оснащенность. Процесс обучения в музыкальной школе включает в себя изучение этюдов, упражнений и гамм. Ежедневное совершенствование технических навыков позволит учащимся более полно передать художественную сторону произведений. Издание включает в себя этюды и упражнения композиторов XVIII-XX веков. Технический материал подобран по степени сложности и отредактирован. Сборник предназначен для использования в учебном процессе учащимися классов гитары ДМШ, ДШИ, а также младших курсов музыкальных колледже
...
Читать дальше »
|

16+ Автор: Гладкий Виталий Дмитриевич Издательство: Вече, 2008 г. Серия: Всемирная история в романах
Аннотация к книге "Басилевс"
На рубеже II-I вв. до н.э. у Римской империи на востоке появился сильный и грозный противник. Царь Понта Митридат VI Евпатор бросил вызов самому могущественному государству мира и в ряде сражений разбил лучших римских полководцев, захватив провинции в Малой Азии и Греции. На протяжении почти сорока лет Басилевс Митридат считался врагом номер один Вечного города и доставил немало хлопот диктатору Сулле, прежде чем тому удалось справиться с отважным и хитрым противником…
|

Автор: Карапетян Гагик, Козловский Александр Редактор: Степаненко Валентина Издательство: Спорт, 2015 г.
Аннотация к книге "С олимпийской занозой в сердце"
Эта книга - своеобразный коллаж, составленный из диалогов признанного российского спортивного дипломата с известным спортивным журналистом, фрагментов документов "для служебного пользования" и малоизвестных публикаций. А.Козловский долгие годы трудился сотрудником Оргкомитета "Олимпиада-80", вице-президентом Олимпийского комитета России и Европейских олимпийских комитетов, членом Оценочной комиссии Международного олимпийского комитета, заместителем председателя Госкомспорта СССР и депутатом Госдумы. Г. Карапетян работал в "Советском спорте", ТАСС, "Неделе", "Труде", "Известиях", "Новых Известиях" и "Русском курьере"
...
Читать дальше »
|

Автор: Максимовский Юрий Михайлович, Аксамит Людмила Анатольевна, Дмитриева Лидия Александровна Редактор: Максимовский Юрий Михайлович, Дмитриева Лидия Александровна Издательство: ГЭОТАР-Медиа, 2015 г. Серия: Национальное Руководство
Аннотация к книге "Терапевтическая стоматология. Национальное руководство"
Второе издание национального руководства по терапевтической стоматологии входит в серию практических руководств по основным медицинским специальностям, включающих всю основную информацию, необходимую врачу для непрерывного дополнительного образования. В настоящем руководстве освещены современные вопросы профилактики, диагностики, фармакотерапии и лечения стоматологических заболеваний в терапевтическо
...
Читать дальше »
|

Автор: Мазин Александр Владимирович Издательство: Астрель, 2012 г. Серия: Перевертыш.2 в 1
Аннотация к книге "Черный стрелок 1. Черный стрелок 2"
"Черный стрелок 1" Алексей Шелехов - наследник изрядного состояния, учится в Англии, пока его опекун управляет промышленной империей погибшего в автокатастрофе отца Алексея. Через полгода Алексею исполняется восемнадцать и он станет полноправным хозяином наследства... Нет, не станет. Оно уже ему не принадлежит. Вдобавок Алексей случайно становится свидетелем еще одной криминальной операции своего опекуна, жертвой которого стала юная девушка, тоже наследница значительного состояния... В течение одного дня молодой аристократ-наследник превращается в дичь, которую травит одни из самых могущественных "князей" Шпргородской области. Но
...
Читать дальше »
|

Автор: Стругова О. Б. Редактор: Максимова А.А. Издательство: ИД Руденцовых, 2013 г.
Аннотация к книге "Дагестан глазами Евгения Лансере"
Московский государственный объединенный музей-заповедник "Коломенское-Измайлово-Лефортово-Люблино" совместно с Дагестанским музеем изобразительных искусств им. П. С. Гамзатовой инициировал уникальный издательский проект - "Дагестан глазами Евгения Лансере". В каталоге, посвященном "кавказскому" периоду творчества выдающегося русского советского художника Евгения Евгеньевича Лансере (1875-1946), представлено более ста произведений графики и живописи, созданных в Дагестане в первой четверти XX века. Кроме того, на страницах издания читатели смогут познакомиться с произведениями декоративно-прикладного искусства горцев.
|

Издательство: Омега-Л, 2009 г. Серия: Кодексы Российской Федерации
Аннотация к книге "Семейный кодекс Российской Федерации на 25.09.09"
Настоящее издание содержит текст Семейного кодекса Российской Федерации по состоянию на 25 сентября 2009 года.
|

Автор: Киселев Александр Константинович Редактор: Жукова Л. Издательство: Белый город, 2010 г. Серия: Энциклопедия мирового искусства
Аннотация к книге "Шедевры фламандской и голландской живописи"
Данное издание представляет фламандское и голландское изобразительное искусство XVII века - "золотого века" нидерландской живописи. Набор персоналий весьма обширен и включает, помимо великих и знаменитых, многих художников, чьи имена, что называется, не на слуху. В описании их произведений сделан акцент на оригинальности тематики и художественной манеры. Рассчитывая на широкий круг читателей, авторы ставили перед собой не столько искусствоведческие, сколько культурологические и просветительские задачи, включая в текст необходимые исторические справки, биографичес
...
Читать дальше »
|

6+ Автор: Бажов Павел Петрович Художник: Бабюк Станислав Валерьевич Редактор: Шишкова И. Л. Издательство: Астрель, 2012 г.
Аннотация к книге "Сказы"
Знаменитые Сказы П.П. Бажова - это особый мир, в котором реальность и фантастика порой неразличимы: там живут голубые змейки и волшебный козлик, и расцветает дивный каменный цветок. О Медной горы Хозяйке, о чудесном мастере Даниле, об Огневушке-Поскакушке, о Серебряном копытце и других героях читайте в этой книге. Для младшего и среднего школьного возраста.
| |
|
|
| Календарь |
| « Сентябрь 2016 » |
| Пн |
Вт |
Ср |
Чт |
Пт |
Сб |
Вс |
| | | | 1 | 2 | 3 | 4 | | 5 | 6 | 7 | 8 | 9 | 10 | 11 | | 12 | 13 | 14 | 15 | 16 | 17 | 18 | | 19 | 20 | 21 | 22 | 23 | 24 | 25 | | 26 | 27 | 28 | 29 | 30 | |
|









